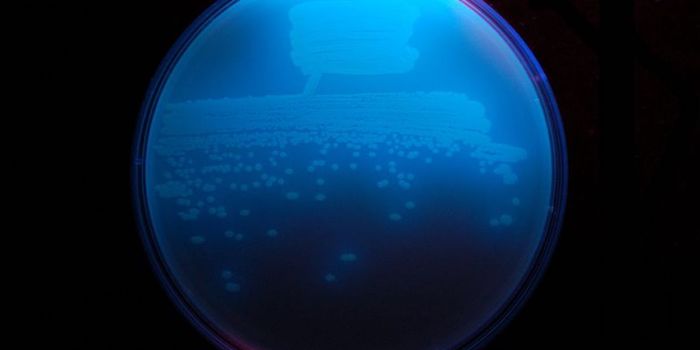
Picturing a New Kind of Antibiotic

X-Ray
X-rays are a type of electromagnetic radiation. X-rays have a higher energy than visible light, allowing them to pass through solid objects like the body. Medical x-rays allow doctors to visualize bones and other tissues inside the body.
-
MAR 10, 2020Space & AstronomyNASA’s OSIRIS-REx mission, a short and sweet acronym for Origins, Spectral Interpretation, Resource Identification ...Written By: Anthony BouchardMAR 01, 2020Space & AstronomyWhen you’re an astronomer, you come to grips with the fact that the job involves a lot of waiting and watching as ...Written By: Anthony BouchardFEB 23, 2020MicrobiologyNoroviruses can contaminate fresh produce and in developed nations, they are the most common cause of gastroenteritis.Written By: Carmen LeitchFEB 04, 2020Space & AstronomyNASA recently retired its Spitzer Space Telescope, one of four specialized space-based observatories that together made ...Written By: Anthony BouchardFEB 02, 2020Space & AstronomyNASA is always sending spacecraft into space to explore the universe around us; be it the close-proximity stellar neighb ...Written By: Anthony BouchardJAN 26, 2020TechnologyAt the 56th Annual Meeting of The Society of Thoracic Surgeons, researchers announced the groundbreaking technology that ...Written By: Nouran AminJAN 22, 2020Clinical & Molecular DXWhat if there was a test that could detect tuberculosis six months before symptoms appear? Researchers at the University ...Written By: Tara FernandesJAN 20, 2020Genetics & GenomicsProtein-coding genes only make up a small part of the genome. Much of the rest may contain long, non-coding RNA sequence ...Written By: Carmen LeitchJAN 09, 2020Chemistry & PhysicsWhen we talk about about particle accelerators, the idea of enormous machines with the size of a warehouse and ...Written By: Daniel DuanJAN 06, 2020Drug Discovery & DevelopmentA study published by PNAS explains breakthrough research around designing drugs that target C. diff bacterial infections ...Written By: Nouran AminDEC 27, 2019Chemistry & PhysicsWhat do the Curie couple, Henrie Becquerel, Louis Harold Gray, and Ralf Sievert, have in common? These radiation pioneer ...Written By: Daniel DuanDEC 22, 2019Clinical & Molecular DXPatients presenting with severe coughs, chest pain or suspected infections are more than likely to be sent for a chest X ...Written By: Tara FernandesNOV 24, 2019MicrobiologyDifferent forms of microbes have been able to make a home even in the harshest conditions. But there are still locations ...Written By: Carmen LeitchNOV 20, 2019Health & MedicineDo you use duvets or pillows filled with goose or duck feathers? While indeed cozy, doctors have issued a new warning re ...Written By: Tiffany DazetOCT 31, 2019Chemistry & PhysicsIt is safe to say that we live in a world of hydrogen and helium, the lightest elements in the periodic table. Born minu ...Written By: Daniel DuanSEP 19, 2019Cell & Molecular BiologyOur cells use proteins as messengers that send or receive critical signals to carry out the functions essential for life ...Written By: Carmen LeitchSEP 11, 2019Health & MedicineSarcoidosis is a multisystem inflammatory disease characterized by the formation of non-caseating granulomas in the ...Written By: Dena ArutaAUG 24, 2019Chemistry & PhysicsThe story of Fast Radio Bursts (FRB) started back in 2007, when Australian astronomer Duncan Lorimer and his student dis ...Written By: Daniel DuanAUG 11, 2019Clinical & Molecular DXAcute respiratory distress syndrome ARDS occurs when fluid builds up in the alveoli. These tiny elastics sacs, which are ...Written By: Abbie ArceAUG 11, 2019MicrobiologyScientists have deciphered the X-ray crystal structure of an enzyme that generates a unique broad spectrum antibiotic ca ...Written By: Carmen LeitchJUL 13, 2019Clinical & Molecular DXIt is estimated that persons suffering from fibromyalgia sometimes wait an average of five years to receive an accurate ...Written By: Abbie ArceJUL 02, 2019TechnologyThe same battery technology utilized in our smartphones and laptops are used in electric cars. These are lithium-ion bat ...Written By: Nouran AminJUN 09, 2019Genetics & GenomicsNo one wants to be exposed to an atomic blast, but studies has shown that the fear of low doses of radiation may be over ...Written By: Carmen LeitchJUN 03, 2019CancerNew research to be presented at the American Society of Clinical Oncology's annual meeting in Chicago this year by a ...Written By: Kathryn DeMuth Sullivan
MAR 10, 2020
Space & Astronomy
NASA’s OSIRIS-REx mission, a short and sweet acronym for Origins, Spectral Interpretation, Resource Identification
...
Written By:
Anthony Bouchard
MAR 01, 2020
Space & Astronomy
When you’re an astronomer, you come to grips with the fact that the job involves a lot of waiting and watching as
...
Written By:
Anthony Bouchard
FEB 23, 2020
Microbiology
Noroviruses can contaminate fresh produce and in developed nations, they are the most common cause of gastroenteritis.
Written By:
Carmen Leitch
FEB 04, 2020
Space & Astronomy
NASA recently retired its Spitzer Space Telescope, one of four specialized space-based observatories that together made
...
Written By:
Anthony Bouchard
FEB 02, 2020
Space & Astronomy
NASA is always sending spacecraft into space to explore the universe around us; be it the close-proximity stellar neighb
...
Written By:
Anthony Bouchard
JAN 26, 2020
Technology
At the 56th Annual Meeting of The Society of Thoracic Surgeons, researchers announced the groundbreaking technology that
...
Written By:
Nouran Amin
JAN 22, 2020
Clinical & Molecular DX
What if there was a test that could detect tuberculosis six months before symptoms appear? Researchers at the University
...
Written By:
Tara Fernandes
JAN 20, 2020
Genetics & Genomics
Protein-coding genes only make up a small part of the genome. Much of the rest may contain long, non-coding RNA sequence
...
Written By:
Carmen Leitch
JAN 09, 2020
Chemistry & Physics
When we talk about about particle accelerators, the idea of enormous machines with the size of a warehouse and
...
Written By:
Daniel Duan
JAN 06, 2020
Drug Discovery & Development
A study published by PNAS explains breakthrough research around designing drugs that target C. diff bacterial infections
...
Written By:
Nouran Amin
DEC 27, 2019
Chemistry & Physics
What do the Curie couple, Henrie Becquerel, Louis Harold Gray, and Ralf Sievert, have in common? These radiation pioneer
...
Written By:
Daniel Duan
DEC 22, 2019
Clinical & Molecular DX
Patients presenting with severe coughs, chest pain or suspected infections are more than likely to be sent for a chest X
...
Written By:
Tara Fernandes
NOV 24, 2019
Microbiology
Different forms of microbes have been able to make a home even in the harshest conditions. But there are still locations
...
Written By:
Carmen Leitch
NOV 20, 2019
Health & Medicine
Do you use duvets or pillows filled with goose or duck feathers? While indeed cozy, doctors have issued a new warning re
...
Written By:
Tiffany Dazet
OCT 31, 2019
Chemistry & Physics
It is safe to say that we live in a world of hydrogen and helium, the lightest elements in the periodic table. Born minu
...
Written By:
Daniel Duan
SEP 19, 2019
Cell & Molecular Biology
Our cells use proteins as messengers that send or receive critical signals to carry out the functions essential for life
...
Written By:
Carmen Leitch
SEP 11, 2019
Health & Medicine
Sarcoidosis is a multisystem inflammatory disease characterized by the formation of non-caseating granulomas in the
...
Written By:
Dena Aruta
AUG 24, 2019
Chemistry & Physics
The story of Fast Radio Bursts (FRB) started back in 2007, when Australian astronomer Duncan Lorimer and his student dis
...
Written By:
Daniel Duan
AUG 11, 2019
Clinical & Molecular DX
Acute respiratory distress syndrome ARDS occurs when fluid builds up in the alveoli. These tiny elastics sacs, which are
...
Written By:
Abbie Arce
AUG 11, 2019
Microbiology
Scientists have deciphered the X-ray crystal structure of an enzyme that generates a unique broad spectrum antibiotic ca
...
Written By:
Carmen Leitch
JUL 13, 2019
Clinical & Molecular DX
It is estimated that persons suffering from fibromyalgia sometimes wait an average of five years to receive an accurate
...
Written By:
Abbie Arce
JUL 02, 2019
Technology
The same battery technology utilized in our smartphones and laptops are used in electric cars. These are lithium-ion bat
...
Written By:
Nouran Amin
JUN 09, 2019
Genetics & Genomics
No one wants to be exposed to an atomic blast, but studies has shown that the fear of low doses of radiation may be over
...
Written By:
Carmen Leitch
JUN 03, 2019
Cancer
New research to be presented at the American Society of Clinical Oncology's annual meeting in Chicago this year by a
...
Written By:
Kathryn DeMuth Sullivan